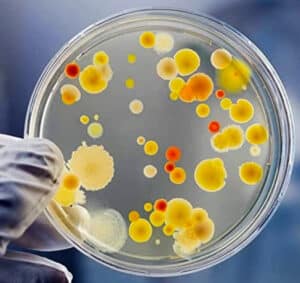

Le mot « Extraterrestre » devrait être une connotation et non pas une dénotation. Il serait plus judicieux de parler « d’humanités différentes ».
Soyons clair, il existe des civilisations extra-terrestres, des civilisations intra-planétaires, et des civilisations intra-terrestre et qui peuvent être multi-dimentionnelles..
- Dans mes articles, je parle de « EBE » pour « Entité Biologique Extraterrestre« .
- Il s’agit en fait de la terminologie utilisée dans les premiers rapports des légistes Américains qui ont autopsiés les cadavres des pilotes de ROSWELL. (Archives Nationales Anglaises).
- À mon humble avis, au sujet de ceux que l’on appellent « Gris », il s’agit en fait d’un « ESE »* « Être Synthétique Extraterrestre »* pourvu d’une conscience qui habite cette « poupée » synthétique, en fait, un robot comme nous saurons les fabriquer dans 50 ans en remplacement de nos robots en « tôle » et silicium.
- *C’est la dénomination donnée par « AIRL » le pilote débriefé par l’infirmière de Roswell.
- Par opposition, nous autres « humains », serions des « ESI » « Entités Spirituelles Immortelles » ce qui est parfaitement logique au regard de la spiritualité. Toujours selon les propos de AIRL.
- CQFD : Nos corps terrestres sont donc aussi des « poupées » jetables habités par une Conscience. L’auteur du site.
- Nous sommes visités par trois formes d’Humanités :
- 1. De véritables civilisations extra-terrestres et/ou intra-planétaires.
- 2. Des civilisations para-terrestres.
- 3. Des civilisations du futur : « EXPLORATION DE L’HUMANITÉ CONTINUE POUR AVANCE PLANÉTAIRE. YEUX POUR VOS YEUX. ANNÉE D’ORIGINE 8100 ».
- Jacques Vallée : « Chronique des apparitions extra-terrestres« .
- « ……Qu’est-ce que tout cela signifie ? Est-il raisonnable de dresser un parallèle entre les apparitions religieuses, la croyance aux fées, les rapports sur des créatures de l’espèce des nains aux pouvoirs surnaturels, les contes de « bateaux aérien » aux États-Unis au siècle dernier, et les histoires actuelles d’atterrissages d’UFO.
- Je soutiendrai volontiers, énergiquement, que c’est raisonnable, pour cette simple raison : que les mécanismes qui ont fait naître ces différentes croyances sont identiques.
- Leur contexte humain et leurs effets sur les humains sont constants. Et ma conclusion est que l’observation de ce très profond mécanisme est cruciale. Il a peu avoir avec le problème de savoir si les UFO sont des objets matériels ou non ».
Officiellement et pour beaucoup de journalistes curés-de-l’info, les soucoupes volantes n’existent -évidemment- pas ! Sauf que le logo du nouvel organisme Américain : « National Intelligence Manager for the Air Domain », soit en FR : « Responsable National du Renseignement pour le Domaine Aérien », ce logo disais-je, comporte une soucoupe volante en plus d’un avion de ligne, un chasseur et d’un drone . Fin de la récréation !!!
Ovnis, PAN, UFO, Crop circle, civilisation extra-terrestre, intra-terrestre, intra-planétaires. Il faut bien avoir en tête que RIEN dans l’ufologie ne peut être expliqué sans l’aide de la spiritualité ! Je dis bien « spiritualité » pas « religion ». La religion est un accident industriel de la spiritualité
C’est cet enseignement que j’essaie de transmettre à travers ces articles.
Toutes les vidéos OVNIS sur ma chaine YOUTUBE

Sans doute, les deux meilleures vidéo à ce jour
Celle-ci n’est pas mal non plus…
Abonnez-vous pour soutenir la revue « IKARIS«
Abonnez-vous pour soutenir la revue « LUMIÈRES DANS LA NUIT »
Les sites que je vous recommande sur YOUTUBE
Je ne re-publie que les vidéos et/ou interview qui sont au vu de mes connaissances : Authentiques, intéressantes, susceptibles de vous faire avancer dans la compréhension du phénomène OVNI et/ou de la spiritualité qui est nécessairement associée. Ce qui ne veux pas dire que je sois d’accord avec toutes les vidéos du site qui publie, notamment le prétendu avion US (au vrai sens Américain du terme » le TR3B qui n’a rien de « Terrien« , du moins pas au sens où on l’entend….
Si votre box et/ou votre télé le permet, je vous conseille de regarder ces vidéos YouTube sur votre télé.
Certaines vidéos peuvent être écoutées en audio, l’image du présentateur ou de l’invité n’apportant rien. Je dis cela pour ceux qui voudraient écouter les interviews dans leur voiture.
« Nous sommes en face d’une technologie qui transforme la physique que nous connaissons et qui est capable de manipuler la réalité en engendrant chez les témoins des états de conscience variées ainsi qu’une altération de leurs émotions et de leurs croyances. Il faut donc que nous analysions de prés cette morphologie du miracle, (NDR. Fatima) aussi soigneusement que nous analysons les roches ramenées de la lune ou les insectes tropicaux. Nous devons démonter cyniquement les témoignages, en chercher les points faibles, et isoler les faits de base. Alors seulement, nous pourrons discuter des motifs et des effets sur la société ». Jacques Vallée. le Collège Invisible. 1975.
« Nos intentions causent des effets dans le futur qui deviennent les futures causes d’un effet dans le présent ». Jacques Vallée.
« …….En effet, Vous vous trouvez ici au cœur même de l’un de ces « disques » (NDR. soucoupes volantes) qui parcourt vos cieux depuis toujours.Ce n’est aucunement un engin ainsi que vos semblables se l’imaginent (NDR. Tôles et boulons), mais bel et bien un être vivant.Nous pourrions le définir comme étant un prolongement de nos consciences ou encore l’objectivation d’un état de notre cœur. C’est pour cela qu’il palpite, qu’il change de forme, s’expanse ou s’amenuise à l’infini ou encore l’objectivation d’un état de notre cœur ou semble disparaître. Il est… de cette réalité qui fait peur à votre humanité et qui fera que certains abandonnerons votre récit à ce point-ci de leur lecture… parce que tout change de couleur. Parce que, enfin, il y a des schémas que vos Gouvernements politiques, scientifiques et religieux ne veulent pas voir s’enraciner sur cette planète… Le sens de la Liberté et de la grandeur de la conscience prendrait trop de place, voyez-vous ! » « Celui qui vient ». Anne Givaudan et Daniel Meurois.
Avertissement
Je re-publie les vidéos qui suivent parce que je les considèrent comme hautement crédibles. Ce n’est pas juste une compilation.
Quand le sage montre un engin non-humain, le GEIPAN et SIGMA-2 regardent le doigt…
Définition d’un scientiste : C’est un poisson rouge qui déclare : « Point de vie possible hors de mon bocal ».
« Les prêtres exorcistes rapportent combien Satan déteste la Vierge Marie et la prière du chapelet, témoignant par là de la force de celui-ci : « Chaque Je vous salue Marie est comme un coup sur ma tête. Si les chrétiens savaient à quel point le rosaire est puissant, ce serait ma fin », dit Satan au père Gabriel Amorth (un exorciste officiel du Vatican). La puissance du rosaire contre les forces du mal pour vaincre les tentations, les vices, les obsessions, etc., est attestée ». Source.
Site recensant les crop circle : Welcome to the Crop Circle Connector
Septembre 2025
Août 2025
Commentaire sur la vidéo ci-dessus : Chers journalistes curés-de-l’info Français, il serait temps de vous BOUGER LE CUL !!!!
Juillet 2025
Solanus Casey, le thaumaturge de la soupe populaire.
Bernard Francis Casey est un citoyen américain, né à Oak Grove, dans le Wisconsin, au sein d’une famille très modeste.
Un tout nouveau livre de Howard Crowhurst ! Pour la première fois, une étude approfondie de la géométrie et des mesures du célèbre zodiaque de Denderah va être présentée au public. Cette œuvre unique, sculptée vers 50 av. J.-C. sur le plafond du temple d’Osiris situé sur le toit du temple de Denderah, dans le sud de l’Égypte, dévoile aujourd’hui ses secrets : tous les éléments de la science sacrée des Anciens se révèlent, au fil des pages. Géométrie sacrée, mesures, astronomie sont réunis dans cette étonnante œuvre d’art objectif, décodée par Howard Crowhurst.
Mon commentaire : La vidéo ci-dessus est calée pour commencer à 25 minutes. Ce qui précède n’a pas vraiment d’intérêt. Je persiste, signe mais ne peut pas en écrire plus, mon article ayant été dégagé du navigateur, ce ne sont pas des drones au sens humain du terme…………
Mon Commentaire : LEGEND propose une émission spéciale OVNIS avec, comme invité, Jean-Jacques Velasco, l’ancien directeur du groupe d’étude des phénomènes aérospatiaux non identifiés pendant 27 ans. Mon seul point de désaccord porte sur la « vague Belge » sinon le reste est exceptionnel et particulièrement bien ASSÉNÉ par l’ancien directeur du GEIPAN !!!
Le Grand Plan de la Troménie de Locronan
Une des plus anciennes cérémonies encore pratiquées en Europe, la procession ou Troménie de Locronan, prend ses racines dans la nuit des temps… Découvrez à travers cette enquête passionnante comment la troménie s’inscrit dans un cadre qui dépasse largement la Bretagne et le christianisme. Fruit de 30 ans d’études et de recherches sur le terrain, ce livre dévoile comment l’implantation du parcours de la Troménie, en relation avec les églises et autres sites sacrés des villages voisins et même les points hauts de Bretagne, répond à une intention commune de l’être humain sur Terre : harmoniser le monde. Contient le plan du parcours de la Troménie, et les détails de chaque station.
Commentaire de la vidéo ci-dessus : Activez les sous-titres en Français. Beaucoup d’informations qui nous manquent, notamment l’activation/désactivation de missiles par des OVNIS : « Prêt au lancement » ou « Lancement en cours » aussi bien chez les Russes que les Américains et ce depuis 70 ans.
Le jour où un OVNI a (NDR. a faillit) lancé un missile nucléaire américain.
Dans une nouvelle interview, Robert Hastings, auteur du célèbre ouvrage UFO and Nukes, explique comment des OVNI ont failli déclencher un holocauste nucléaire sur le sol américain. Commentaire : La traduction du titre est débile !!!! L’OVNI a « seulement » activé la procédure de lancement.
Juin 2025
Le « Deep State » tente-t-il de bloquer les lois et les enquêtes sur les PAN au Congrès ?
De nouvelles informations révélées par notre partenaire Ask a Pol suggèrent que l’opposition à l’enquête du Congrès sur les PAN provient de fonctionnaires « hostiles » au sein du Deep State.
Commentaire de la vidéo ci-dessus : Témoignages exceptionnels à écouter en ce relaxant. Certains témoignages sont une leçon de vie.
Un nouveau rapport affirme que des membres d’équipage de la marine ont été irradiés lors de la récupération d’un OVNI. Dans leur livre blanc, les auteurs affirment qu’une opération de récupération d’un OVNI dans le Pacifique a contaminé du personnel militaire.
Le livre dont il est fait état dans la vidéo ci-dessus :
Le Code Secret de l’Architecture: La révélation
« L’auteur de ce livre a mis au jour l’existence d’un vaste Code qu’il a découvert dans l’architecture ancienne. Les châteaux et les cathédrales les plus connus sont concernés. Au-delà du cadre architectural proprement dit, il a existé -il existe encore- des personnalités comme Léonard de Vinci, Nostradamus, François Mitterrand, qui ont codé leurs œuvres. Ce volumineux dossier intègre la figure de Jésus-Christ. De grands secrets de civilisation ont été connus par des initiés qui appartenaient à une société secrète. Les messages qui ont été déposés se retrouvent dans une démarche intellectuelle saine. Le décodage utilise les déductions logiques, la langue française, les nombres, le logiciel Google-Earth. Peut-on savoir où est cachée l’Arche d’Alliance ? L’Atlantide, a-t-elle été une civilisation évoluée de la préhistoire ? Des extraterrestres, ont-ils eu des contacts avec la royauté française ? Cette affaire révolutionnera le monde quand l’heure sera venue. Ce livre de 748 pages contient des centaines d’images ».
https://youtube.com/shorts/5j56s5ZuoHo?si=fF1NAsyrXne6JZEo
Commentaire de la vidéo ci-dessus : J’ai publié un commentaire sur cette interview volontairement tronquée de ces éléments les plus intéressants dans l’actualisation de Juin 2025 de cet article.
Commentaire de la vidéo ci-dessus : Comme toujours avec cette chaîne YOUTUBE, une interview exceptionnelle et très enrichissante pour les chercheurs qui savent écouter très attentivement….
Commentaire de la vidéo ci-dessus : Ces boules ont fait l’objet de vidéos dans cet article. Hier soir quand j’ai regardé cette vidéo et appris l’existence d’une deuxiéme boule, je me suis dit : Sûr que la Colombie va être touchée par un séisme. Ça n’a pas raté, ce matin : Colombie : un tremblement de terre de magnitude 6,5 a secoué Bogota.
Piqure de rappel : Edgar Cayce parle d’un séisme en Amérique du Sud qui créera un nouveau passage entre l’Atlantique et le Pacifique, un canal de Panama naturel en quelque sorte…
https://www.youtube.com/shorts/rYXfdC28IpA
https://youtube.com/shorts/758itNbXmms?si=DPt2QBr6xRfYxHp2
Commentaire sur l’article ci-dessus : J’ignore qui se cache derrière cette chaine YouTube : « L’Almanach des Mystères » mais ce sont de sacrés clients !!!!!
https://www.youtube.com/shorts/iefjx0OVlR8
Mai 2025
Commentaire de la vidéo ci-dessus : Activez les sous-titres en Français.
Commentaire sur l’article ci-dessus : Intéressant même si je ne suis pas d’accord sur tout. Notamment sur l’assertion selon laquelle les américains posséderaient des technologies anti-gravité ou possédant des véhicules ARV (Alien Reproduction Vehicule), « Reproduction de Véhicule Extra-terrestre ». Comprendre : Rétro-ingénierie.
En Angleterre, le premier crop circle de l’année vient d’être découvert. C’est près de Sutton Veny, dans le Wiltshire, que le premier cercle de culture de l’année a été repéré. Et abondamment commenté.
Commentaire sur l’article ci-dessus : Vidéo intéressante, j’espère que Baptiste n’a pas trop censuré les 3 heures de l’original. Il parle notamment d’Ingo SWAN dont j’ai commenté le livre « Pénétration » dans cet article :
Ufologie. « Ils n’étaient pas seuls sur la Lune ». « Pénétration psy ».
Un document déclassé de la CIA décrirait des emplacements de bases Aliens
Commentaire sur l’article ci-dessus : Le document émane VRAIMENT du site officiel de la CIA, voici le lien : https://www.cia.gov/readingroom/docs/CIA-RDP96-00789R003800190001-0.pdf
Bases secrètes en Alaska, et ailleurs, n’étonnera pas les chercheurs. La question est comment, pourquoi, ce document se retrouve en accès libre sur le site officiel de la CIA. Le directeur de la CIA ne peut pas ne pas être pré-informé de la divulgation de ce document. S’agit il d’un début de divulgation ? Je note que ce mémo a été rédigé en 1987, sous la présidence REAGAN et ça c’est un indice important, car il lui était certainement destiné. Un document a en son temps fuité : « le briefing de Reagan ».
Commentaire de la vidéo ci-dessus : J’ai un peu hésité à reprendre cette interview, mais bon on est pas d’accord sur des points de détail. Autant dire de suite que j’ai quelques arguments pour confirmer que les documents MAJESTIC 12 sont authentiques. Simplement Nael PARKS ne connait pas suffisamment le milieu militaire pour en comprendre le cheminement et les codes.
Un détail parmi d’autres ! Luis Elizondo n’est pas « retraité » mais démissionnaire du Pentagone et à ce titre il a perdu ses droits à la retraite. Ce n’est pas pareil !!!
MAJESTIC 12 n’est pas un « machin anti-démocratique ». C’est un organisme créé de toute urgence au temps de Truman, (comme la CIA a été créé juste après Roswell pour en assurer la gestion) et qui est composé de personnalités scientifiques, militaires, civiles, ayant un cerveau capable d’encaisser des révélations qui feraient péter le cerveau du citoyen lambda et provoquerait une guerre civile ! Ce n’est pas anti-démocratique, c’est une opération de salubrité publique.
Commentaire de la vidéo ci-dessus : Voici le commentaire que j’ai laissé sur le site et qui ne sera surement pas publié ! Trop « radioactif » sans doute ! : « Les appareils TR3B ne sont pas humains au sens où vous l’entendez ils ne sont pas américain ni russe ni chinois. Ils sont d’une race intra-terrestre qui intimide et tiens à distance une confrontation nucléaire entre grandes puissances ».
Cette dénomination : « Immaculée Constellation » est une des nombreuses dénomination du saucissonnage du secret servant à nommer des intelligences non-humaines. Seulement voilà…. Cette dénomination « Immaculée Constellation » n’est pas sans rappeler l’apparition de Lady Marie à Lourdes sous la dénomination : « Je suis L’Immaculée Conception ». Ceux qui ont choisi ce nom savaient parfaitement ce qu’ils font, ils savent parfaitement le rapport spirituel qu’il y a entre : Intelligences non-humaines, Intra-terrestre, Maitres Ascensionnés et les représentants de la Race Bleue.
Lire à ce sujet mon dernier article :
Avril 2025
Commentaire sur la vidéo ci-dessus : J’ai envoyé un commentaire particulièrement sanglant à Baptiste le créateur de SENTINEL NEWS. On ne pas prétendre résumé une interview aussi ESSENTIELLE que celle de Harald MALMGREN en ayant des PUDEURS DE JEUNES DE FILLES OU PLUTÔT DE SCIENTISTE, parce que ce dernier évoque au milieu du sujet ovnis, l’Ordre de Malte, les Templiers ou l’assassinat de Kennedy. Selon les dires de Baptiste, « c’est radioactif » !!!!
Ce n’est pas radioactif Baptiste, cela s’appelle de « L’ésotérisme gouvernemental » tout comme le MAJESTIC 12.
Harald MALMGREN qui a fait partie du MAJESTIC 12 (déclaration parallèle de sa fille) dit que pour l’assassinat de Kennedy , « l’hypothèse N°1 est effectivement en lien avec les OVNIS. »
Cette note déclassifiée de Kennedy demande une plus grande coopération avec les Russes sur la question OVNIS : (10 jours après JFK était assassiné !)
Harald MALMGREN confirme 3 jours avant sa mort et dans cette interview : « Kennedy voulait parler ouvertement du sujet OVNIS avec les Russes. Faire baisser l’armement nucléaire et faire la Paix ». Il ajoute que dans le traité SALT 1, le sujet des ovnis est clairement abordé. Explications : Russes et Américains ont déjà eu des alertes nucléaires en confondant une flotte OVNIS qui volaient en formation et qui se dirigeaient vers eux en prenant cela pour une attaque de l’autre. Le passage concernant les OVNIS dans le traité SALT 1 ne devrait pas être difficile à trouver, sous réserve de connaitre les mots clé utilisés, UFO par exemple .
Baptiste passe sous silence le crash de Roswell et des informations essentielles telles que le pilote de Roswell aurait livré des informations sur les armes à énergie dirigée à utiliser contre les ovnis !!! A mon humble avis, AIRL, le pilote de Roswell n’a rien donné comme informations scientifiques, il le dit lui même dans son interview avec l’infirmière avec qui il a sympathisé : « Je suis un officier, je ne parlerai pas, voici mon nom et mon matricule ». Par contre il est possible que les scientifiques américains en est déduit une technologie basée sur une explosion à base de rayons X pour faire tomber les OVNIS… Technologie qu’ils ont testée… En l’occurrence une arme à énergie dirigée.
Baptiste, vous avez « oublié », disons plutôt que votre côté scientiste a éliminé un point essentiel, un des points les plus important de l’interview : La fille de Harald MALMGREN dit que « l’Occident, les États-Unis, l’Europe » (j’y ajoute tous les crétins de scientistes) « ….ont un gros problème avec le système cartésien qui ne permet pas aux scientifiques d’étudier les phénomène ovnis, mystiques, etc, alors que la mysticisme, l’aspect spirituel ne pose aucun problème avec la Russie, la Chine et l’Inde ils n’ont aucun problème à l’aborder d’un point de vue mystique et spirituel ». C’EST CLAIR !!!!!!! ??????
Baptiste ne parle pas non plus de ce que l’on a appelé « la guerre des étoiles » de Reagan. Harald MALMGREN confirme que c’était une énergie « DUALE » conçue non pas contre les Russes mais contre une attaque extra-terrestre et basé sur des rayons X. Les Russes c’était un leurre !!!!
Voici le logo de L’IDS : « Initiative de Défens Stratégique », « Guerre des étoiles » selon les journalistes curés-de-l’info, telle que voulu par REAGAN. Il ne faut pas être très malin pour voir que ce bouclier est largement éloigné de la Terre et donc qu’il sert à protéger la Terre. Il faut savoir, peu de gens le savent, mais REAGAN a de façon quasi certaine fait l’objet d’une abduction en Californie AVANT sa présidence. C’est documenté et argumenté !
Le logo de l’IDS est à comparer avec celui du « National Intelligence Manager for the Air Domain », soit en FR : « Responsable National du Renseignement pour le Domaine Aérien », ce logo comporte une soucoupe volante en plus d’un avion de ligne, un chasseur et d’un drone . Fin de la récréation !!!
Voici le commentaire que j’ai laissé sur la vidéo et qui ira certainement à la poubelle : « Vu la façon dont vous avez raccourci l’interview je me suis coltiné les 4 heures d’interview pour voir ce que vous avez volontairement blacklisté ou plutôt ce que vos pudeurs de scientistes ont évacues : Vous avez volontairement ignoré les déclarations selon lesquelles le pilote survivant de Roswell leur a donné une information pour abattre d’autres ovnis en se servant des armes à énergie dirigées. Vous avez volontairement oublié qu’il confirme que Kennedy a bien été assassiné à cause du phénomène ovnis et qu’il voulait partager les connaissances avec les les Russes : « Hypothèse numéro 1″. Vous avez volontairement passé sous silence les connexions avec l’Ordre de Malte. Je comprends que pour un scientiste, ça n’a rien à voir avec des ovnis. Contrairement à ce que vous pensez, si tout ce pedigree des services secrets pointe à l’Ordre de malte c’est pas pour faire joli. Mais on en reparlera avec l’actualité prochaine………. En conclusion, il vaut mieux une transcription littérale qu’un soi disant résumé qui évite tous les sujets qui VOUS dérangent… »
Voici ci-dessus l’interview de Harald MALMGREN trois jours avant sa mort.
En ce qui me concerne, la vidéo est authentique d’autant plus que son auteur s’est identifié lui même. Elle possède des détails qui recoupent d’autres informations.
Commentaire de la vidéo ci-dessus : Toute les conneries, toutes les âneries , tous les poncifs par des journalistes ou plutôt des curés de l’info. A écoutez, on va rigoler bientôt….!!!!
Une vision de l’enfer sauve John Pridmore.
« À la fin du XXe siècle, John Pridmore est une grande pointure du crime organisé londonien. Il est devenu riche grâce au trafic de drogue. Très redouté, il a toujours une arme sur lui et s’en sert régulièrement. Mais, un jour, dans son appartement, il entend Dieu l’avertir gravement : s’il continue ainsi, il ira en enfer… Terrifié par la vision qu’il a de l’enfer, il comprend la gravité de sa situation et change radicalement : aujourd’hui, il mène une vie de services et de témoignages à travers le monde pour faire connaître ce que le Christ a fait pour lui. »
La troublante affaire de l’ovni écossais jamais élucidée.
Un étrange losange suspendu dans les airs : des clichés pris par deux randonneurs en Écosse constituent, pour le journal “The Guardian”, les meilleures photos d’engin volant non identifié jamais produites. L’affaire est remontée jusqu’au ministère de la Défense. Mais trente-cinq ans plus tard, l’énigme reste entière. Les promeneurs, eux, sont introuvables.
Epstein, JFK, ovnis… Anna Paulina Luna, la femme qui pourrait lever tous les secrets. À 35 ans, l’élue républicaine à la Chambre des Représentants Anna Paulina Luna a été nommée à la tête d’une « task-force » en charge de la « Déclassification des secrets fédéraux ». Au programme, des dossiers emblématiques comme celui de l’assassinat de John F. Kennedy, l’affaire Epstein ou encore les ovnis.
Une gigantesque structure a-t-elle été découverte sous les pyramides de Gizeh ? Des scientifiques italiens ont annoncé avoir détecté grâce à une méthode d’imagerie radar une structure démesurée sous les pyramides de Gizeh. Mais la communauté archéologique est très loin d’être convaincue… Commentaire : Le jour ou cette salle connue des chercheurs et des mystiques depuis des milliers d’années sera découverte, c’est un peu comme si on découvrait un avion RAFALE dans la grotte de LASCAUX….!!!
Mars 2025
Le miracle de Calanda : du moignon à la jambe !!!!!!!
En juillet 1637, en Aragon, en Espagne, le paysan Miguel Juan Pellicer est victime d’un accident qui lui fracture le tibia. Sa blessure s’infecte et s’aggrave, si bien qu’en octobre, il est amputé de la jambe droite à l’hôpital de Saragosse. Rentrant chez lui, il rejoint sa famille et mendie, son infirmité ne lui permettant plus de travailler. Deux ans plus tard, dans la nuit du 29 mars 1640, il se réveille en ayant à nouveau deux jambes.
Commentaire de la vidéo ci-dessus : Il vaut mieux lire mon article qui est autrement plus intéressant et qui contre-enquête sur de nombreux points :
https://www.chasseurdesanglier.com/le-livre-alien-interview-entretien-avec-lalien-traduit-en-francais-linfirmiere-qui-a-debriefe-le-pilote-du-crash-de-roswell/
Commentaire de la vidéo ci-dessus : Intéressant pour ceux qui ne connaissent pas le sujet, par contre les conclusions sont pour le moins débiles : Considérez qu’il s’agit de prototypes secrets d’un état lambda, oui c’est débile !!!!!
Pentagon ‘still mystified’ as drone drama deepens. Faites faire la traduction par votre navigateur. C’est époustouflant !! : « …….Malgré cela, des « dizaines » d’objets inconnus et brillés ont volé en toute impunité au-dessus d’une base critique de l’armée de l’air pendant 17 nuits en 2023. Idem pour une série d’incursions audacieuses sur des bases militaires américaines sensibles au Royaume-Uni l’année dernière. Au cours de ces incidents, les témoins ont signalé des dizaines de véhicules en embarcations très éclairées « envolées » et présentant des caractéristiques de performance extrêmes tout en évitant la détection et de multiples systèmes avancés de contre-drones. »
« ………..Ces engins énigmatiques démontrent également une dynamique de vol déconcertante qui surpasse toute technologie connue. Pendant plusieurs mois en 2019, par exemple, des objets avec des lumières clignotantes brillantes ont envahi certains des navires de guerre les plus avancés de la marine au large des côtes du sud de la Californie, souvent bien plus de 100 miles au large. »
Commentaire de la vidéo ci-dessus : Quand on a perdu ses deux enfants à trois ans d’intervalle on a pas besoin de faire plus de commentaires, juste à écouter et à lire son livre……..
J’ai trouvé cet article journal LIBÉRATION (publié le 16 juillet 2024 à 16h34) qui vit grassement des subventions de L’ÉTAT-PROVIDENCE, autrement dit ces cochons de Français…. : « Pas si étrange : les ovnis, pas forcément «objets», pas forcément volants, et souvent identifiables ». « Nombre de phénomènes mystérieux et dons extraordinaires ont bien souvent été expliqués ou démystifiés par la recherche. Aujourd’hui, parlons un peu « soucoupes volantes »… »
On est « rassurés » d’apprendre que les témoins dont beaucoup sont des pilotes militaires et civiles confondent la planète Vénus et un disque lumineux ou un cigare argenté avec des hublots……..
C’est le même journal qui a publié ceci :
Commentaire de la vidéo ci-dessus : Le « Michel Audiard de la spiritualité » a encore frappé avec cette citation attribuée à Bernard Tapie : « Les Français, c’est pas compliqué, tu les enculent une fois, ils te suivent toute la vie ».
Stanley Villavicencio, Lazare des temps modernes.
Le 2 mars 1993, Stanley Villavicencio est amené en catastrophe à l’hôpital Chong Hua de Cebu City (Philippines). Malgré les soins des médecins, il tombe dans le coma. Maintenu en vie grâce à divers appareils, il est finalement déclaré cliniquement mort. Son cœur s’arrête, aucun organe vital ne donne le moindre signe d’activité et son teint prend une teinte terne… Trois jours plus tard, dans les couloirs de l’hôpital, il flotte dans l’air un mélange d’excitation et d’incrédulité. L’homme, qui a été déclaré cliniquement mort soixante-douze heures plus tôt, se lève du lit et s’en va comme n’importe quelle personne en bonne santé.
« En 1996, le sénateur du Nevada Harry Reid était invité par son ami George Knapp, journaliste et présentateur de la chaîne de télévision KLAS-TV de Las Vegas, à une réunion du conseil d’administration de la fondation NIDS, présidé par son fondateur Robert Bigelow. Lors de cette réunion, il fit connaissance avec Colm Kelleher, qui parlait au nom de NIDS.
En 2007, Robert Bigelow informa Harry Reid d’une lettre qu’il avait reçue d’un scientifique de la Defense Intelligence Agency (DIA), le Dr Jim Lacatski, qui demandait l’autorisation de visiter le ranch de l’Utah dont Robert Bigelow avait fait l’acquisition.
Le chef de la majorité au Sénat, Harry Reid, estima alors qu’il était temps d’adopter une approche scientifique de la question de l’UAP. Il organisa une réunion confidentielle avec deux sénateurs membres de la commission des crédits du « budget opaque », Ted Stevens, sénateur de l’Alaska, et Daniel Inouye, sénateur d’Hawaï.
C’est ainsi qu’est né l’AAWSAP, programme d’applications des systèmes d’armes aérospatiaux avancés (Advanced Aerospace Weapon System Applications). Le budget alloué était de 22 millions de dollars et, après un appel d’offres officiel, c’est la société de Robert Bigelow qui a obtenu le contrat.
Le programme est resté inconnu du public jusqu’au 16 décembre 2017 et la publication d’un article du New York Times, « Glowing Auras and « Black Money » : The Pentagon’s Mysterious U.F.O. Program »
L’article du New York Times mentionnait que le contrat de 22 millions de dollars avait été attribué à Bigelow Aerospace, mais ignorait complètement le programme AAWSAP, en raison d’une grave méprise qui donnait un poids disproportionné au programme AATIP, un projet informel autorisé par le Pentagone.
Le 4 août 2020, le secrétaire adjoint à la défense David Norquist a approuvé la création de l’UAP Task Force (UAPTF), dont la mission était de détecter, d’analyser et cataloguer les phénomènes aériens non identifiés susceptibles de constituer une menace pour la sécurité nationale des États-Unis. Le 25 juin 2021, l’Office of the Director for National Intelligence (ODNI) publiait un rapport novateur sur les conclusions de l’UAPTF ».
Harry Reid a commenté le rapport de l’ODNI : « Mais tout cela n’est qu’une goutte d’eau dans l’océan (…) nous disposons de rapports militaires et civils sur les PAN en Amérique au cours des 70 dernières années, ainsi que de rapports provenant du monde entier.
Les origines du rapport de l’ODNI remontent à 2008, treize ans avant la publication du rapport. Ce livre revient sur les premières étapes de ce parcours, et décrit la mise en œuvre et la portée du plus grand programme officiel d’étude des PAN aux États-Unis (2008-2010) par l’agence de renseignement de la défense américaine (DIA). »
Février 2025
Commentaire de la vidéo ci-dessus : J’ai laissé un commentaire dont je ne suis pas sûr qu’il soit publié : « Toujours intéressant.
Par contre quelques « objections » :
1. Le remote wieving si vous le pratiquez pour aller dans des endroits ésotériquement secrets vous risquez de grosses emmerdes ! Il suffit de lire en Français « espions psy » au sujet des remote wiever de la CIA et de ce qu’ils disent au sujet de leurs « rencontres » avec des extra-terrestre. Ils ne veulent plus y toucher !!! »
2. Message pour Guillaume : « Militaires » ne signifie pas automatiquement « terriens » ni « armée française ». Comprenne qui pourra ! Ce n’est pas parce qu’on porte une combinaison avec un insigne que l’on est « militaire », c’est une interprétation du remote wiever.
3. Idem pour les hélicoptères, ils ne sont pas forcément « armée française »………….. ;-))))
4. « activités 100 % humaines ». Elles sont 100 % humaines….oui….. mais de quels humains on parlent ???? ;-)))
Commentaire de la vidéo ci-dessus : 33 minutes de documents vidéos époustouflants !
Commentaire de la vidéo ci-dessus : grâce à Sylvain Didelot, j’ai découvert l’auteur de ces musiques absolument extraordinaires crées par Didier GAUTIER.
Le directeur de la CIA John Ratcliffe lâche une bombe sur les PAN/OVNI
Janvier 2025
Commentaire de la vidéo ci-dessus : WAOUH !!! Que dire….???? Exceptionnel, tout simplement exceptionnel comme toutes les interviews de Sylvain Didelot.
Commentaire de la vidéo ci-dessus : Intéressant ! On commence à sortir des tôles et boulons chinoises de chez SENTINEL NEWS……
Je viens de terminer cet excellent livre : « Le quatrième secret de Fatima »,
qui m’a permis de comprendre cette énigme des crânes de cristal mais aussi de celle de la fabrication des ovnis qui ne laissent pas entrevoir une construction « mécanique ». Au chapitre : « Les apparitions de Fatima et la physique de l’information » page 210-211, Daniel Robin nous explique cela de façon très claire : « …..Une telle physique (NDR. de l’information) serait peut-être capable de fabriquer des objets simplement en « ordonnant », (NDR. en précipitant) selon un plan et un programme précis, l’information de la matière. Pour fabriquer un objet de consommation courante (voiture, machine à laver, ordinateur, etc.) nul besoin d’utiliser des usines comme celles que nous connaissons aujourd’hui pour fondre les pièces, les souder entre elles, et assembler les composants électriques et électroniques pour parvenir au résultat souhaité. Il suffirait d’agir directement au niveau de l’information qui est l’autre face de la matière/énergie pour arriver au même résultat. Pour soigner les êtres vivants, le procédé serait le même. Nul besoin de fabriquer des médicaments ou d’injecter des substances chimiques dans le corps, le traitement s’effectuerait directement au niveau de l’information. Les fractures seraient réduites par le même procédé. Dans le cas des organismes vivants je suppose que c’est le même processus qui se produit lors d’une guérison miraculeuse à Lourdes, à Fatima, ou lors de la rencontre avec un OVNI. Nous y voyons un « miracle » alors que le procédé réside dans la maitrise de la physique de l’information. »
Commentaire de la vidéo ci-dessus : C’est la vérité……… OUI ! Sauf que c’est une autre dimension inatteignable si on ne vibre pas à cette fréquence. Comme je l’écrivais dans un autre article : Ce n’est pas parce qu’on parle allemand « sous » l’Antarctique et que l’on a des svastikas que l’on est « nazis ». Ce sont les nazis qui se sont emparés du symbole multi-millénaire de la Svastika, pas le contraire.
Commentaire de la vidéo ci-dessus : Un historien militaire parle. C’est le meilleur historique qu’il m’est été donné à voir.
Commentaire de la vidéo ci-dessus : Prodigieux documentaires sur les crop circle en Angleterre.
Je rajoute à la liste des sites que je vous recommande sur YOUTUBE :
AMEDCINE TV : « Le XXIe siècle sera spirituel ou ne sera pas » A.Malraux ✨ Magazine & Podcast sur la médecine de l’âme Plateforme de référencement en soins quantiques et holistiques.
Commentaire des deux vidéos ci-dessus : Le livre qu’elle a écrit :
Manuel pratique pour avancer plus sereinement sur votre chemin d’incarnation et d’évolution spirituelle ! Peut-être vous demandez-vous pourquoi vos relations amoureuses ou amicales ne sont pas durables et constructives ? Ou bien encore vous étonnez-vous de ne pas réussir à conserver un emploi, de manquer d’argent ou de ne pas avoir une santé optimale ? Si vous ressentez des freins récurrents ou des schémas qui se répètent inlassablement, cela peut découler de contrats d’âme – provenant de vies antérieures –, encore actifs dans votre vie actuelle.
En effet, selon le principe de réincarnation, notre âme s’incarne de vie en vie afin de poursuivre son évolution spirituelle. Cependant, certaines expériences peuvent ralentir ou entraver son cheminement, créant des dettes karmiques dont il est nécessaire de se libérer. Des blocages peuvent également prendre source dans de fortes croyances erronées, ou suite à des émotions violentes ou répétées. Grâce à ce manuel pratique et interactif, vous serez en mesure de réaliser facilement un véritable check-up de votre âme. Vous y découvrirez des clés, des exercices et des solutions concrètes pour épurer votre karma, et vous libérer des blocages qui entravent votre vie.
Anne de Guigné, la petite fille qui parlait à Jésus. En 1932, l’évêque d’Annecy décide d’instruire la cause de béatification d’Anne de Guigné, morte une décennie plus tôt, le 14 janvier 1922. L’étonnant est que la servante de Dieu a dix ans et demi à sa mort ; jusque-là, les seuls enfants portés sur les autels étaient des martyrs. Un récit très émouvant !
Commentaire des deux vidéos ci-dessus : Toutes les interventions de Marc Auburn sont passionnantes !!!
Commentaire des deux vidéos ci-dessus : Un documentaire passionnant !!!!!!!
Commentaire des deux vidéos ci-dessus : Je découvre Marc AUBURN et je le trouve très, très intéressant.
La Passion de madame Rolande Lefebvre à Ermont, près de Paris, jusqu’en l’an 2000. « Rolande Lefebvre est une mystique française contemporaine encore peu connue qui, toute sa vie, a voulu rester très cachée, mais qui a obéi à son directeur spirituel en acceptant d’écrire le récit de sa vie spirituelle extraordinaire, qui sera publié en 1993 sous le titre La Passion de Madame « R », journal d’une mystique assiégée par le démon. Après une enfance difficile, des vœux religieux non aboutis et de fréquentes maladies, Rolande est guérie en 1938 à Lourdes de manière étonnante. Elle se marie, a des enfants et vit très discrètement, en mère de famille, toutes les étapes de la vie mystique, jusqu’au mariage spirituel en 1972. »
Ce témoignage est exceptionnel parce qu’il date de notre époque, de maintenant et qu’on ne pourra pas dire qu’il n’y a pas de preuves scientifiques puisque les noms de professeurs de médecine qui ont validés ce cas extraordinaire sont parfaitement connus : Extrait de l’article : ………..Le jeûne absolu de Rolande est contrôlé à l’hôpital pendant quarante-sept jours, du 22 avril au 7 juin 1980, notamment par le docteur Philippe Loron, médecin de la Pitié-Salpêtrière. Le jeûne total d’eau entraîne normalement la mort en six jours maximum. Le docteur Louis Callerot, cardiologue, constate que, malgré le jeûne absolu, Rolande a pris du poids et que plusieurs phénomènes observés chez elle se situent « en dehors de la physiologie normale ».
Je suis abonné à la newsletter du site et je reçois tous les jours cette lettre : « Toutes les raisons d’y croire ». Je dois dire que hier soir avant de me coucher j’ai reçu une nouvelle particulièrement mauvaise et que la lecture de ce récit ce matin, m’a redonné l’espoir qu’il me fallait pour me relever. Ce que j’apprécie dans ces cas que je qualifierai de « contemporain » c’est que les preuves scientifiques ne manquent pas même si elles ne sont pas relayés par France Inter et France 2, le service prétendument « PUBLIC »……..
Commentaire des deux vidéos ci-dessus : Deux autres interviews par rapport au livre : « Pardonner à la mort ». Passionnant !
Commentaire de la vidéo ci-dessus : Une interview EXCEPTIONNELLE à tous égards !!!!!!!!!
Quand le FBI enquêtait sur Bigfoot, le yéti américain.
Des documents déclassifiés montrent que le service américain a analysé des poils suspectés d’appartenir à la légendaire créature, cousine de l’abominable homme des neiges.
Commentaire de la vidéo ci-dessus : Témoignage personnel et intéressant de Geneviève Delpech. Encore plus intéressant la sélection d’orbes filmés et diffusés sur TIC TOK. A noter que moi aussi j’ai vu un orbe en mer il y a 17 ans de cela. Il suivait la ligne des bouées, donc 300 mètres. Vu qu’il n’y avait pas de vent, j’ai tout de suite suspecté quelque chose et j’ai attendu qu’il passe dans le cône de la lumière de la lune pour bien le voir. Il n’y avait aucune structure autour et il était comme éclairé de l’intérieur. Bizarrement, ma pensée a été : « Il cartographie la côte ». Je n’ai jamais pu élucider cette vision, sinon qu’il était à la hauteur de ce qui pourrait être une brutale montée des eaux en Méditerranée. Affaire à suivre…..
Commentaire de la vidéo ci-dessus : Interview donnée à l’occasion de la sortie de ce livre INCONTOURNABLE :
Commentaire de la vidéo ci-dessus : Écoutez et réécoutez attentivement ce que dit Sylvain Didelot, notamment : « révélations dans tous les sens du terme« , « le ciel pourrait bien rejoindre la terre dans tous les sens du terme ».
Commentaire de la vidéo ci-dessus : Superbe reportage. En fait, tous les reportages de 100% DOCS sont très, très bien !!!
Commentaire de la vidéo ci-dessus : Quel bonheur de pouvoir retrouver ce documentaire sur cette affaire qui reste à ce jour le cas le PLUS DOCUMENTE ET LE PLUS ÉTUDIÉ en ce qui concerne la réincarnation.
Commentaire de la vidéo ci-dessus : Excellent !
Spiritualité : Abbé Albert MONET ✝ « Prières d’hier et d’aujourd’hui ».